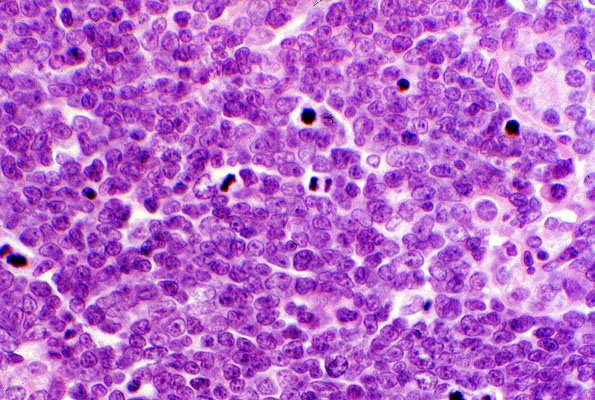

non-Hodgkin lymphoma, lymphoblastic, histology
Click picture to enlarge. Close window to return
This slide shows a monotonous population of neoplastic cells which have fine chromatin and lack nucleoli. Note the high mitotic rate. Lymphoblastic lymphoma is a high grade lymphoma, and represents the solid tissue counterpart of acute lymphoblastic leukemia.